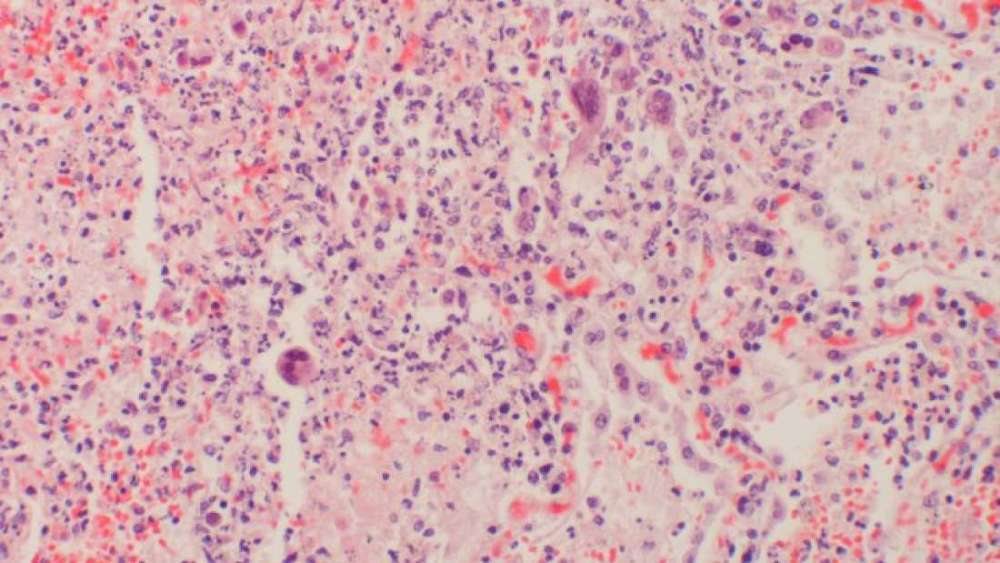

Iată câteva mituri despre sex care nu ar trebui să mai existe:
Vaginul unei femei se lărgeşte dacă aceasta are mai mulţi parteneri
Există foarte puţine dovezi care să ateste că relaţiile intime pot extinde vaginul femeii, de asemenea nu se schimbă culoarea, forma sau mărimea în funcţie de numărul de parteneri sau frecvenţa actului sexual. După cum explică medicul Sari Locker, ,,este un mit faptul că vaginuldevine extins permanent din cauza sexului cu un partener cu un penis de dimensiuni mari. După fiecare relaţie sexuală vaginul se contractă la mărimea sa iniţială”.
În cadrul unui studiu din 2016, publicat în revista Human Reproduction, cercetătorii au studiat mărimea şi forma medie a vaginului prin intermediului RMN-ului. Aceştia au declarat că ,,anatomia vaginului a fost studiată foarte puţin ”. Au descoperit că nu există un mod de caracterizare a formei vaginului, fiecare având dimensiuni diferite.
Ejacularea feminină este falsă sau forţată

O credinţă comună este că ejacularea feminină ar fi nenaturală şi deviantă. Din punct de vedere ştiinţific, este vorba de o altă funcţie biologică. În cadrul unui studiu s-a descoperit faptul că între 10% şi 40% dintre femei experimentează degajarea unui jet de urină atunci când ajung la orgasm. Însă în cadrul unui studiu mult mai mic s-a studiat compoziţia lichidului şi s-a descoperit că ejacularea feminină apare involuntar, ca un jet de urină. În alte cazuri, cercetătorii au descoperit o cantitate de antigen prostatic specific, o chimicală care se regăseşte în ejacularea masculină.
Bărbaţii înalţi cu picioare mari au un penis cu dimensiuni peste medie

Cel mai comun mit despre penis se referă la mărimea acestuia în funcţie de rasă. În cadrul unei analize profunde din 2015, au fost analizate 15.521 de mărimi de penis din întreaga lume. Mărimea medie a penisului care nu este în erecţie a fost de 9,16 centimetri. În Nigeria, lungimea medie a fost de 8,16 centimetri, în India 8,21 centimetri, în Coreea de Sud mărimea medie a fost de 7,7 centimetri şi în Statele Unite ale Americii mărimea medie a fost de 8,85 centimetri.
Circumcizia penisului poate afecta funcţiile sexuale
Penisurile circumcise nu îşi pierd sensibilitatea sexuală. În cadrul unui studiu publicat în revista The Journal of Urology au fost observaţi 62 de bărbaţi cu vârsta cuprinsă între 18 şi 37 de ani. Dintre aceştia, 30 erau circumcişi şi 32 nu erau circumcişi. Cercetătorii au măsurat sensibilitatea tactilă a penisurilor. Rezultatele au fost asemănătoare în cazul ambelor grupuri.
Himenul unei femei ,,se rupe” după primul act sexual
Forma şi structura himenului diferă de la o femeie la alta, însă în general acesta este alcătuit dintr-o membrană subţire care acoperă parţial interiorul vaginului. Desigur, se poate rupe după primul contact sexual, dar nu este un lucru atât de comun. Deoarece nu are nicio funcţie fiziologică, acesta a fost asociat cu puritatea şi virginitatea în multe culturi.
Herpes-ul
Herpesul are o reputaţie proastă din multe motive, însă 90% dintre oamenii planetei au herpes.
Herpesul se regăseşte în opt forme. Însă cel mai îngrijorător este herpesul de tip 1 şi virusul herpetic de tipul 2 care apare deseori în sezonul rece. Conform Organizaţiei Mondiale a Sănătăţii, aproximativ 2,7 miliarde de oameni sub vârsta de 50 de ani sunt infefctaţi cu virusul herpetic de tip 1.
Sursa: IFL Science
Vă recomandăm să citiţi şi următoarele articole: